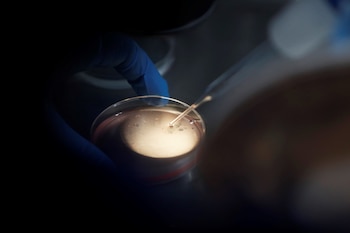
El mismo equipo que los

Como si se tratara de una novela gráfica de ciencia ficción, se registró el primer nacimiento de unos robots llamados xenobots en Estados Unidos, los cuales fueron hechos con células de rana.
Los xenobots son bio robots milimétricos que pudieron replicarse a partir de ellos mismos. Los investigadores de las universidades de Vermont, Tufts y Harvard señalaron que en el 2020 los primeros en su tipo fueron ensamblados desde células de rana.
Dichos organismos fueron diseñados en computadora y ensamblados a mano; pueden nadar en una placa de petri, encontrar células individuales y reunir cientos de ellas, informó la Universidad de Vermont a finales de noviembre pasado.
Estos robots que pueden tener “hijos” tienen forma de Pac-Man y mantiene dichas células dentro de su “boca”, además son capaces de ensamblar en ella “bebés” que se ven y mueven de la misma forma que ellos. Días después de unos días “gestación” nacen los nuevos xenobots, los cuales pueden salir y construir copias de sí mismos una y otra vez.
Según Joshua Bongard, informático y experto en robótica de la Universidad de Vermont que codirigió el estudio, si dichos robots tienen el diseño adecuado, se pueden autorreplicar espontáneamente.
Las células embrionarias en una rana xenopus laevis se convertirían en piel, pero el equipo las colocó en un contexto novedoso, para darles “la oportunidad de reimaginar su multicelularidad”, dando lugar a algo muy diferente, agregó Michael Levin de la Universidad de Tufts.
Aunque las células tienen el genoma de una rana, al ser “liberadas de convertirse en renacuajos, usan su inteligencia colectiva, una plasticidad, para hacer algo asombroso”, agregó Lavin.
Por su parte, San Kriegman de la Universidad de Vermont, principal autor de la investigación, dijo que el xenobot “madre” está compuesto por unas 3.000 células que forman una esfera que tras “reproducirse” muere.

“Estas pueden hacer ‘hijos’, pero después el sistema normalmente se extingue. En realidad, es muy difícil conseguir que el sistema siga reproduciéndose”, dijo. “Estas son células de rana que se replican de una manera muy diferente a cómo lo hacen las ranas. Ningún animal o planta conocida por la ciencia se replica de esta manera”, continuó.
No obstante, con un programa de Inteligencia Artificial (AI), un algoritmo evolutivo fue capaz de probar miles de millones de formas corporales en simulación -triángulos, cuadrados, pirámides, estrellas de mar- para encontrar las que permitían a las células ser más efectivas en la replicación “cinemática”, basada en el movimiento, de la que trata la nueva investigación.
De ese modo, los científicos desarrollaron un programa para que un superordenador ajustara la forma inicial de xenobot progenitor. Luego de meses de trabajo y probar varios diseños, encontraron que el parecido a Pac-Mac era el más adecuado para el desarrollo de la parte biológica.

La replicación cinemática es bien conocida a nivel de moléculas, según los autores, pero nunca se había observado a escala de células u organismos completos. Ante la posible preocupación de algunas personas a la biotecnología autorreplicante, los investigadores dijeron que su objetivo es más profundo que la replicación.
“El mundo y las tecnologías están cambiando rápidamente. Es importante, para la sociedad en su conjunto, que estudiemos y comprendamos cómo funciona”, aseguró Bongard.
Asimismo, aseguró que estas máquinas vivientes son de tamaño milimétrico y están “contenidas por completo en un laboratorio, fácilmente extinguibles y examinadas por expertos en ética”.
En ese sentido, dijo que estos pequeños biorobots no le quitan el sueño como lo es el riesgo de otra pandemia, la aceleración del daño a los ecosistemas o la intensificación de las amenazas por el cambio climático.
(Con información de Reuters y Europa Press)
SEGUIR LEYENDO:
Últimas Noticias
Salir de un grupo de WhatsApp en modo incógnito es posible
La actualización está activa para iPhone y teléfonos Android

Apple Music lanza “Replay”, una lista de canciones preferidas cada semana
La recopilación de canciones favoritas será actualizada cada domingo hasta el final del año 2023

Inteligencia artificial elimina marcas de agua en fotografías
Según WatermarkRemover, estos sellos que garantizan los derechos de autor también arruinan la estética de las fotografías

Así se puede usar un iPhone como traductor de idiomas, sin internet
La aplicación de Traducción se encuentra instalada de forma predeterminada en los celulares de Apple y puede descargarse desde la App Store

Juegos de rol en TikTok: “escoge tu aventura” es el nuevo desafío
Los usuarios aprovechan las herramientas de la red social para proponer escenarios entretenidos a sus seguidores



